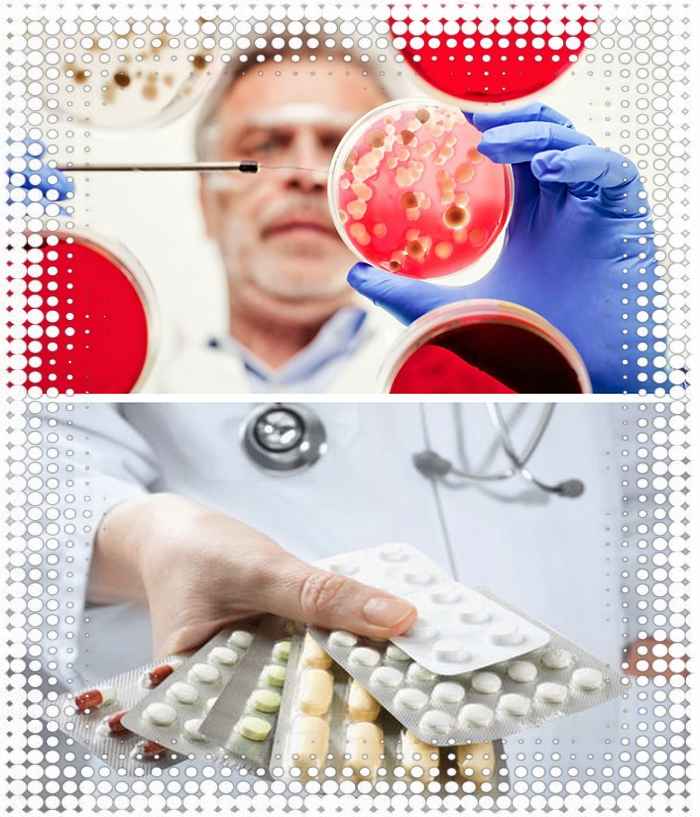
image

Среди недостатков тетрациклинов часто называют их побочные эффекты: нефротоксичность, диспепсические явления, повышение внутричерепного давления, головокружение, угнетение кроветворения, токсический гепатит и другие. Также препараты данной группы нарушают формирование костной ткани, поэтому их нельзя назначать детям, беременным и кормящим мамам. Наиболее часто используют:
- тетрациклин;
- доксициклин («Доксибене», «Вибрамицин», «Юнидокс»).
Принимают доксициклин по 0,1 г один или два раза в сутки. Советуется дополнительно проводить контроль функции почек и печени каждые 3 дня приема препарата.
Пенициллины
Препараты пенициллинов имеют ограниченное использование при цистите. Это обусловлено снижением эффективности из-за развития стойкости у микроорганизмов.
Сейчас назначают препараты амоксициллина с клавулановой кислотой («Аугментин», «Панклав», «Амоксиклав»).
Среди побочных эффектов часто отмечают расстройства пищеварения, которые быстро проходят после завершения приема лекарства. Длительность применения пенициллинов при цистите до 7 суток.
med-antibiotiki.ru
Медикаменты, используемые для устранения других урологических недугов
Врачи назначают антибиотики для лечения цистита, руководствуясь следующим перечнем требований к данному виду лекарственных препаратов:
- Высокая эффективность против основных возбудителей цистита. Зачастую развития заболевание бывает спровоцировано кишечной палочкой или стафилококком. Реже встречается протей, энтерококк и клебсиелла. Прием антибиотика должен способствовать прекращению роста патогенной микрофлоры. В редких случаях болезнь может развиваться из-за наличия в организме вируса герпеса, грибковых заболеваний, а также паразитов. Традиционные антибиотики для лечения цистита абсолютно неэффективны против гельминтов или вирусных возбудителей.
- Антибиотики должны оказывать щадящее действие на микрофлору кишечника. Во время лечения должна уничтожаться только патогенная микрофлора. Часто после курса антибиотиков врачи назначают пробиотики для восполнения потерянных бактерий кишечника. Особенно тяжело дисбактериоз переносится людьми с ослабленным организмом и детьми.
- Максимальная концентрация лекарства должна наблюдаться именно в органах мочевыделительной системы. Благодаря этому будет достигаться хороший терапевтический эффект.
- Отсутствие раздражения со стороны слизистой оболочки желудка и наличие защитной оболочки антибиотика для предотвращения разрушения под воздействием желудочного сока.
- Кратность приемов препарата, должна быть удобной и иметь такое пролонгированное действие, благодаря которому пациент быстро бы восстанавливал свой привычный распорядок дня.
- Низкая вероятность развития аллергических реакций после приема препарата.
Препарат также должен хорошо переноситься пациентом и при необходимости комплексного лечения сочетаться с другими противовоспалительными препаратами.
Если у человека развилась другая болезнь, поразившая почки, каналы, выводящие мочу или ткани мочевого пузыря, то врачи могут рекомендовать больному следующие медикаменты:
- Канефрон — его назначают при наличии у пациента признаков цистита, пиелонефрита или гломерулонефрита. Особенно хорошо это лекарство действует при поражении почек. Антибиотик позволяет за короткое время устранить воспаление, вызванное микроорганизмами. Но лекарство не всегда помогает, если болезнь переходит в хроническую стадию.
- Нолицин — этот медикамент врачи рекомендуют использовать для снятия острых и хронических инфекционных поражений. Препарат позволяет сравнительно быстро устранить болевые ощущения. Он может убивать бактерии и вирусы, которые невозможно устранить другими лекарствами.
- Палин используется при наличии у больного признаков пиелонефрита, пиелита, уретрита, цистита и других подобных заболеваний. Микроорганизмы, вызывающие урологические болезни уничтожаются этим антибиотиком за довольно короткий срок.
Для лечения урологических заболеваний нельзя употреблять ранее используемые лекарственные средства. Бактерии и микроорганизмы уже выработали от них защиту, поэтому такие препараты будут бесполезны, а в ряде случаев даже опасны, так как будут способствовать развитию хронической стадии недуга. Поэтому нельзя заниматься самолечением. Только врач может подобрать нужное для больного лекарство.
Больные должны правильно применять антибиотики, которые выписал врач. Надо точно соблюдать дозировку препарата, рекомендованную доктором, строго выдерживать количество дней применения медикамента. Пить лекарство нужно даже тогда, когда все признаки заболевание исчезли, но врач не дал команды на прекращение использования лекарства.
Антибиотики во время урологического поражения надо принимать каждый день в одно и то же время. Это способствует поддержанию концентрации лекарства в организме пациента на постоянном уровне, что очень важно для устранения инфекции. Запрещено применять совместно с урологическими антибиотиками алкоголь, так как находящиеся в нем ингредиенты разрушают структуру лекарства.
nefrolab.ru
Когда пить лекарства
Прежде чем начать пить антибиотики, нужно знать тип воспалительного процесса. Он может быть полипозным, катаральным, некротическим, кистозным, язвенным. Форму определяет врач, предварительно выслушав мужчину на предмет жалоб. Доктор оценивает симптоматику, изучает результаты анализов, и только после этого может точно назвать тип воспаления.
Антибиотики при цистите у мужчин назначаются только после сдачи всех анализов. Если пациент без ведома врача начинает принимать антибиотики, это может спровоцировать переход острого воспаления на хронический этап. Тогда лечение будет постоянным.
Антибиотиками лечат острое и хроническое воспаление. Терапия проводится в условиях стационара. В лечебный курс входит прием лекарств и травяных отваров. Также показана физиотерапия совместно с промыванием пораженной полости мочевого пузыря.
На данный момент линейка таких лекарственных средств достаточно обширна, поэтому подобрать необходимое лечение не составит труда.
Одним из представителей данной группы препаратов является 5-НОК. Давайте рассмотрим свойства этого средства подробнее.
Лекарственное средство 5-НОК – это препарат из фармакологической группы оксихинолинов, относится к уросептикам. Как правило, применяется для лечения воспалительных и инфекционных заболеваний мочеполовой системы.
Для нитроксолина уязвимы многие вредоносные микроорганизмы. Среди них:
- стафилококки,
- кишечная палочка,
- стрептококки,
- уреплазма,
- микроплазма,
- кандида,
- плесневые грибки,
- дерматофиты,
- некоторые грибы, которые вызывают глубокие микозы,
- сальмонелла,
- протей,
- трихомонада и другие.
Поэтому 5-НОК относится к лекарственным средствам широкого спектра действия.
Особенности активного компонента препарата обусловливают механизм его действия. Попадая в организм человека, нитроксолин блокирует размножение возбудителей заболевания путем угнетения синтеза ДНК в их клетках.
Помимо этого, препарат также нарушает окислительно-восстановительные и дыхательные процессы в клетках вредоносных микроорганизмов, тем самым способствуя их нейтрализации.
После применения препарата, максимальная концентрация его активного вещества в организме достигается уже через 1-2 часа, т. к. нитроксолин хорошо абсорбируется в желудочно-кишечном тракте, что способствует скорейшему наступлению положительного эффекта от лечения.
Метаболизируется преимущественно в печени и выводится с мочой и желчью.
Следует отметить, что в моче концентрация препарата достаточно высокая, что также позволяет быстрее излечивать заболевания мочевыводящей системы.
Принимавшие 5-НОК пациенты утверждают, что препарат достаточно эффективен и хорошо справляется с поставленной задачей.
Однако не следует выбирать этот препарат, не посоветовавшись с врачом и не сдав предварительно анализы, т. к. если возбудители болезни нечувствительны к нитроксолину, входящему в состав препарата, положительного эффекта от применения не будет.
Многие врачи рекомендуют параллельно с 5-НОК принимать поддерживающие иммунитет препараты, которые смягчат действие антибактериального средства и в целом укрепят организм.
5-НОК выпускается в лекарственной форме таблеток (двояковыпуклые, круглые). Каждая таблетка покрыта оранжевой оболочкой.
Состав:
- нитроксолин – 50 мг в таблетке;
- вспомогательные компоненты:
- моногидрат лактозы,
- кукурузный крахмал,
- гидрофосфат кальция,
- диоксид кремния коллоидный,
- очищенный тальк,
- кросповидон и другие;
компоненты оболочки: сахароза, очищенный тальк, кукурузный крахмал, диоксид титана, красители.
Благодаря лекарственным свойствам препарата, он широко применяется в урологии для лечения острых и хронических заболеваний мочевой системы.
5-НОК показан при:
- цистите (остром, хроническом, вторичном, посттравматическом);
- уретрите;
- эпидидимите;
- иных воспалениях мочевого пузыря и мочевыводящей системы;
- пиелонефрите (как острый, так и хронический);
- простатите, а также инфекционных заболеваний предстательной железы (аденома, карцинома) и даже раке предстательной железы;
- орхите.
Помимо этого, 5-НОК используется и как средство профилактики при частых рецидивах инфекционных заболеваний мочеполовой системы, а также для предотвращения инфицирования после хирургического или иного медицинского (катетеризация, цистоскопия) вмешательства в работу почек и органов мочевой системы.
Как и любой сильнодействующий антибактериальный препарат, 5-НОК имеет ряд противопоказаний.
Если какой-либо из нижеперечисленных случаев имеет место, следует сообщить об этом врачу, чтобы он скорректировал курс лечения.
5-НОК противопоказан при:
- печеночной и почечной недостаточности (в тяжелой форме);
- катаракте;
- повышенной чувствительности или непереносимости компонентов препарата или хинолинов в целом.
Также данное средство, как правило, не назначают детям возрастом до 3 лет. Исключение возможно только в очень тяжелых случаях, когда другая терапия не помогает. Но применение должно проходить под контролем врача.
Что касается лечения препаратом 5-НОК в период беременности, то на данный момент отсутствуют подтверждения безопасности средства для плода, поэтому оно назначается только в крайних случаях.
В период лактации препарат лучше заменить другим средством или отказаться от грудного вскармливания на все время применения 5-НОК.
Не следует принимать данный препарат пациентам, страдающим непереносимостью фруктозы, недостаточностью лактозы и сахарозы-изомальтазы.
Рекомендуется принимать препарат во время или после еды, чтобы снизить риск расстройства пищеварения. Таблетку проглатывают не разжевывая, запивают достаточным количеством воды.
Определять дозировку и порядок применения должен только врач.
Как правило, стандатная дозировка для взрослых пациентов составляет 400 мг препарата в день, разделенные на несколько приемов. При необходимости дневная доза может повышаться до 800 мг.
Детям до 5 лет назначают до 200 мг препарата в сутки, старше 5 лет – до 400 мг. Что касается пациентов, чей возраст меньше 3 лет, то дозировка рассчитывается индивидуально, исходя из веса ребенка.
Пациентам, страдающим почечной или печеночной недостаточностью не назначают более половины обычной дозы, т. е. до 200 мг препарата в день.
Длительность лечения, как правило, составляет 2-4 недели. Курс может быть продлен по рекомендации врача, но только после предварительного анализа функционирования почек и печени.
При цистите назначают 100-150 мг препарата в сутки. Курс лечения составляет до 3х недель.
Когда 5-НОК назначается как средство профилактики, как правило, следует принимать по 100 мг препарата до 4х раз в сутки.
Передозировка
Риск передозировки минимален. При приеме очень большой дозы препарата возможна боль в животе, тошнота, рвота. Пациенту необходимо дать активированный уголь, промыть желудок. Дальнейшее лечение осуществляется согласно симптомам.
Практика применения показывает, что 5-НОК хорошо переносится пациентами, побочные эффекты проявляются достаточно редко. Однако, о них следует знать, чтобы в случае появления неприятных симптомов прекратить принимать препарат.После отмены средства все негативные реакции организма прекращаются.
Побочное действие 5-НОК на различные системы организма.
- Нервная система: головокружение, головные боли, редко нарушение координации движений и ухудшение зрения, атаксия.
- Сердечно-сосудистая система: тахикардия, тромбоцитопения, повышение содержания мочевой кислоты в крови.
- Пищеварительная система: тошнота, рвота, нарушение нормальной работы печени, потеря аппетита, анорексия.
- Также возможны аллергические реакции (зуд, сыпь), общая слабость, онемение кожи конечностей.